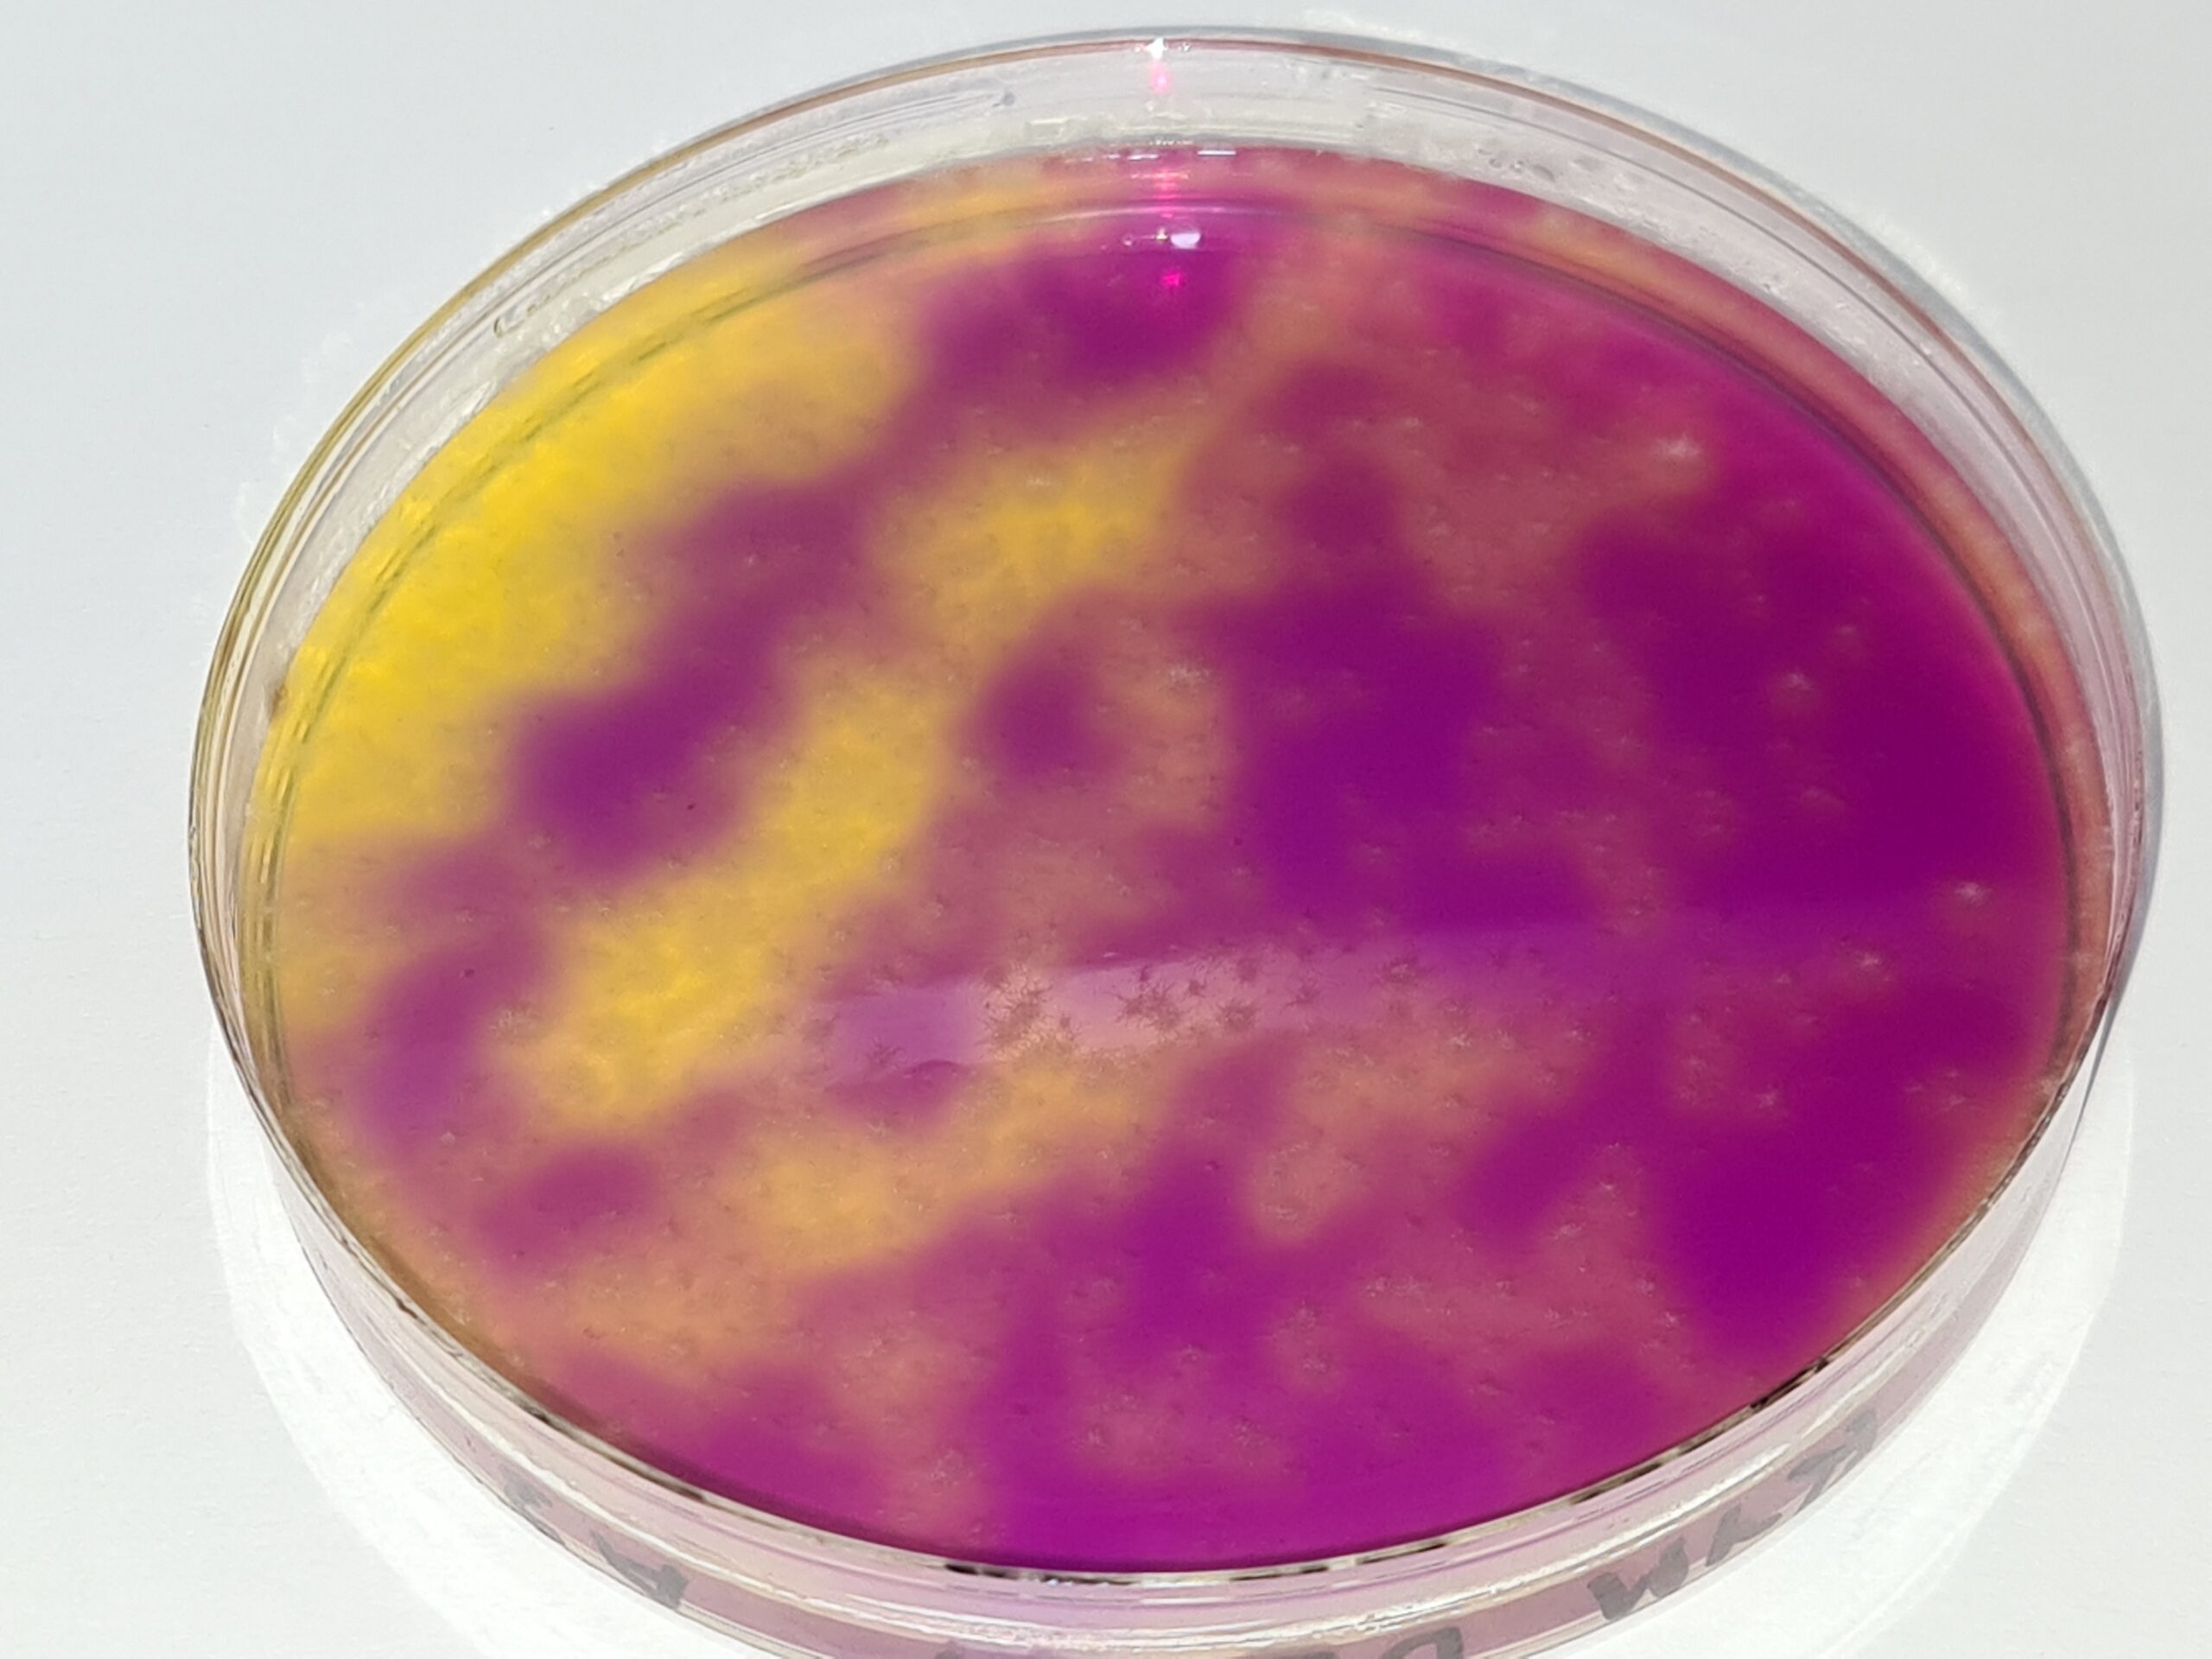
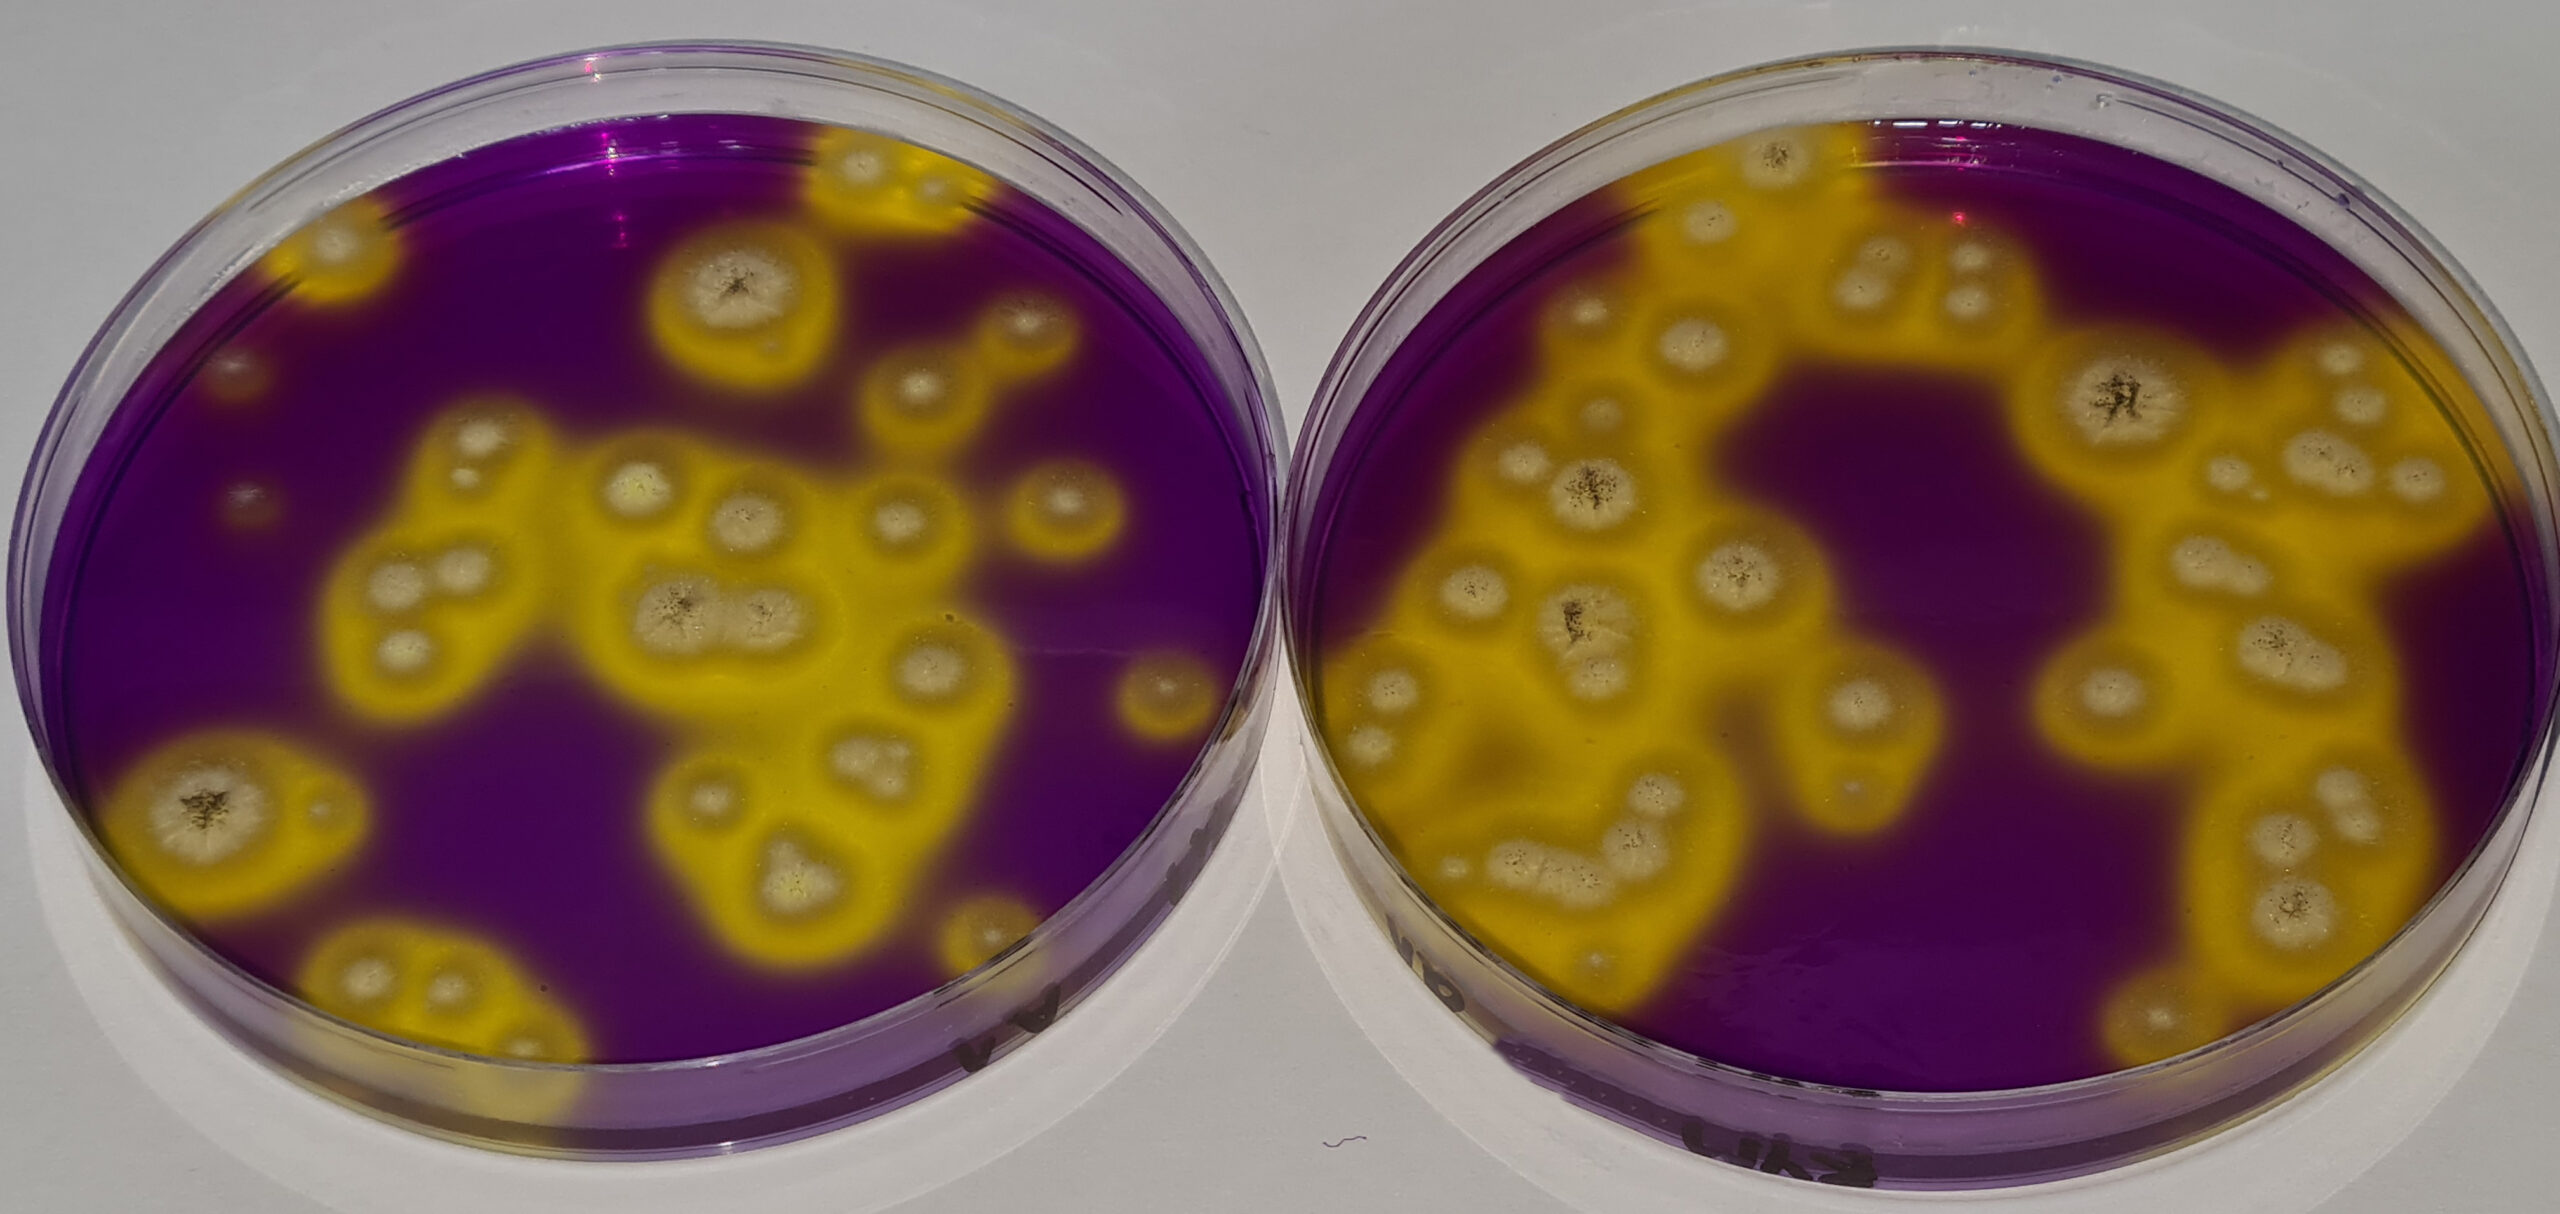
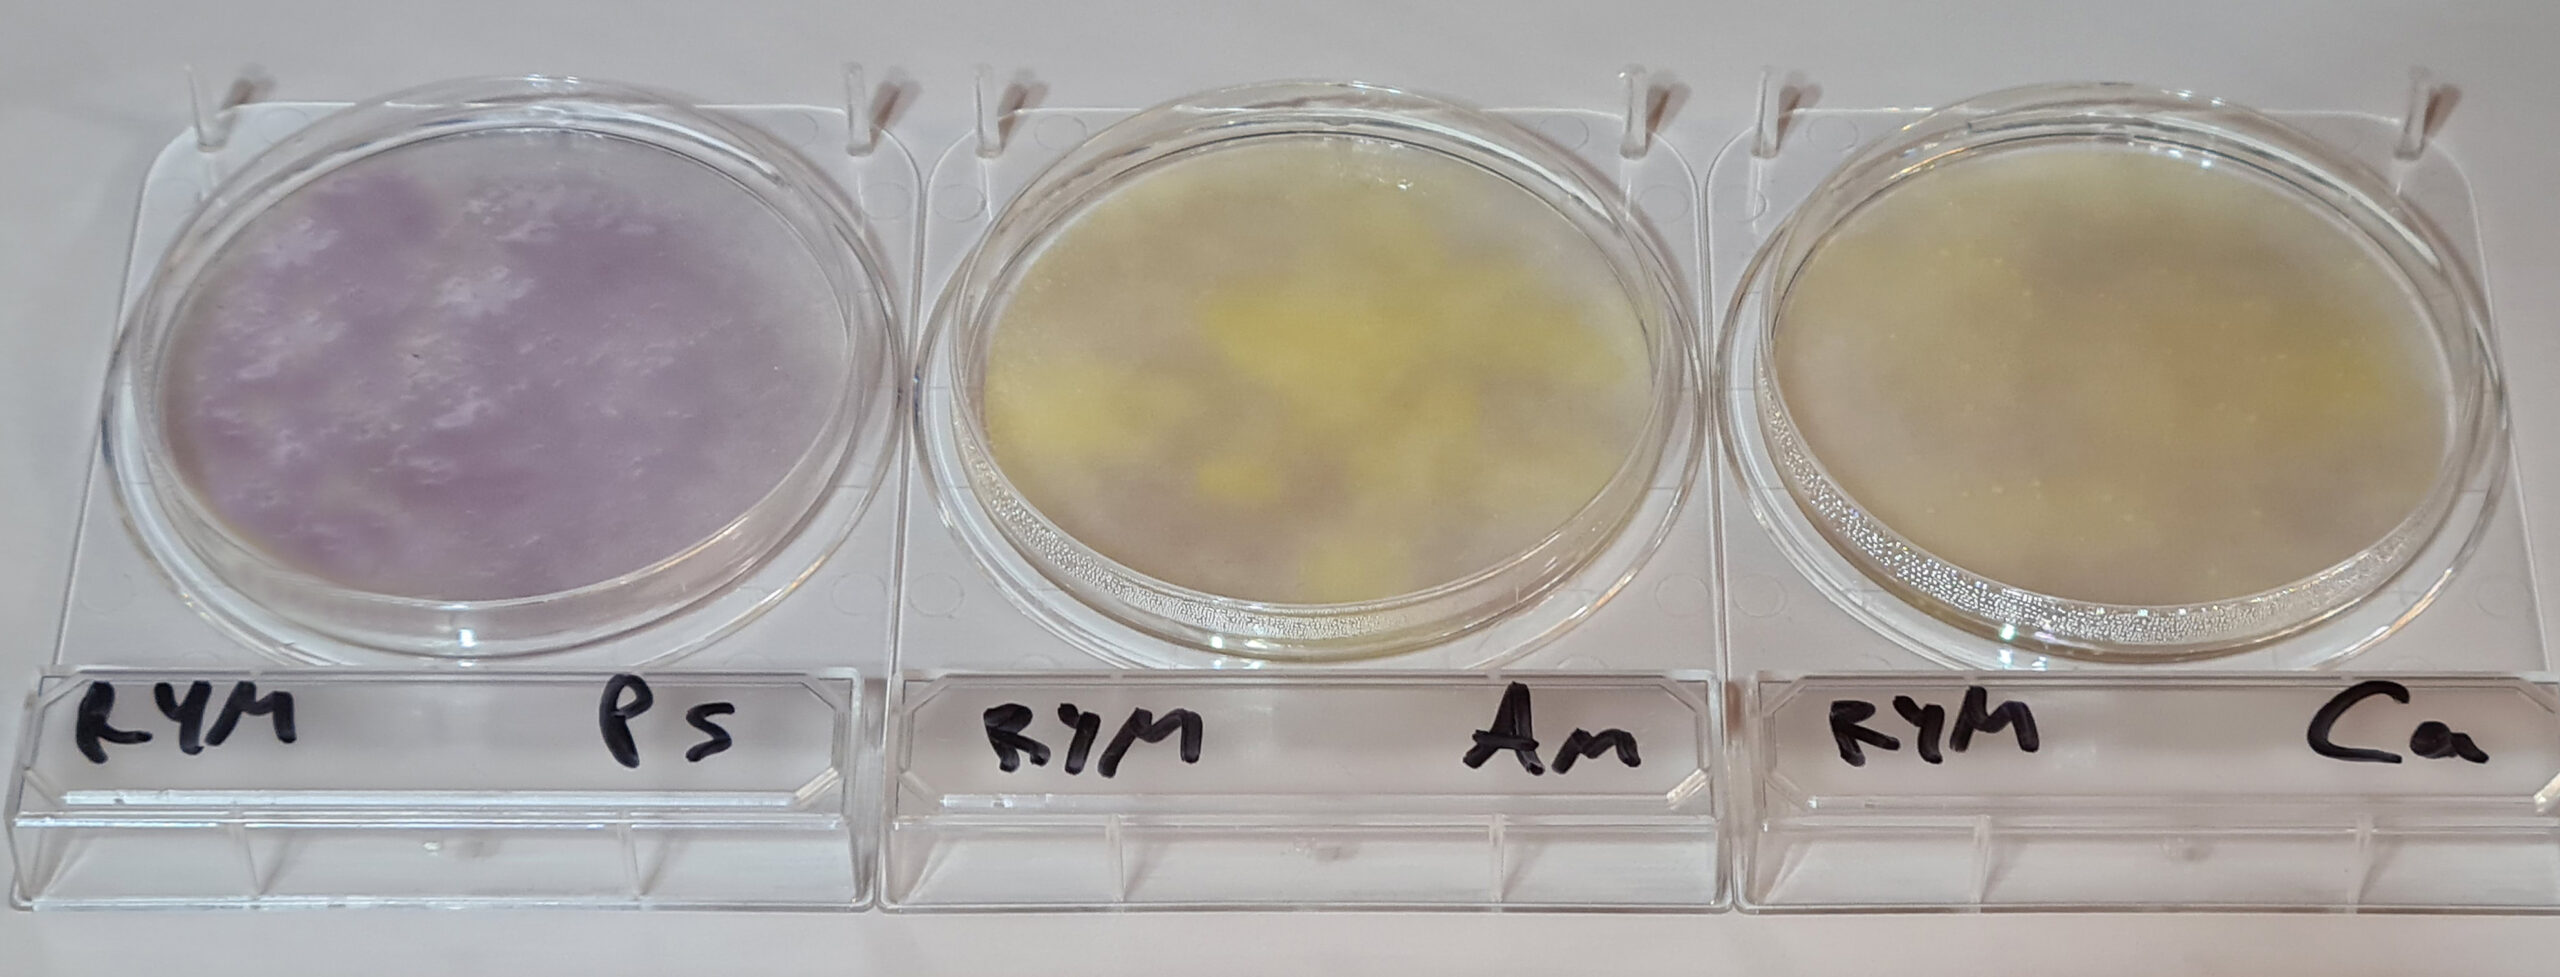

RECUENTO DE HONGOS EN COSMÉTICOS, MÁS FIABLE Y MÁS RÁPIDO, SIN INVERSIÓN EN EQUIPOS PARA TÉCNICAS ESPECIALES
RECUENTO DE HONGOS (LEVADURAS Y MOHOS) EN COSMÉTICOS, MÁS FIABLE Y MÁS RÁPIDO, SIN INVERSIÓN EN EQUIPOS PARA TÉCNICAS ESPECIALES
Rapid Sabouraud RYM Agar (base Sabouraud) permite contar en cosmética colonias con halo amarillo sobre fondo violeta, distinguiéndolas de partículas de muestra y en sólo 18-36 horas. Siempre se trata de hongos (levaduras y mohos), ya que las bacterias quedan completamente inhibidas.
Las validaciones realizadas sobre este medio, tanto por MICROKIT como por los laboratorios que lo emplean, demuestran estas tres afirmaciones:
1-Aumenta la fiabilidad,
ya que las colonias crecen con su aspecto típico y ademas un halo amarillo alrededor, sobre el fondo violeta del medio, lo que permite contrastar respecto al color crema del clásico Sabouraud. Esto además ayuda a forzar/desgastar mucho menos la vista de los analistas al realizar los recuentos de levaduras y mohos. Las partículas de muestra y burbujas no son interpretadas como colonias falsamente positivas. Y las colonias diminutas no pasan desapercibidas como falsos negativos.
2-Permite mayor comodidad al analista,
por lo ya explicado sobre el contraste de las colonias con halo amarillo sobre el medio violeta (ver fotografía)
3-Aumenta la rapidez de resultados,
ya que precisamente ese mismo contraste halos/medio, se hace patente mucho antes de la aparición de las colonias: ¡desde las primeras 18 horas! En s´lo 18 h ya sabremos si vamos a tener hongos en la placa y en sólo 36 horas ya podremos hacer el recuento de levaduras y mohos.
Candida albicans crece en las primeras 18 horas en RYM Agar con este inconfundible aspecto blanco-verdoso que la distingue de otras levaduras, que siempre dan falso positivo en otros medios
Aspergillus niger se detecta en las primeras 18 horas con estos halos amarillos sobre el fondo violeta del medio
Y sus colonias ya se ven, algunas incluso esporulando (centro negro), en las primeras 36 horas
Rapid Sabouraud RYM Agar tambien está disponible en las cómodas placas deshidratadas DryPlates-RYM: siembra en masa de 1 mL sin tener que calentar ni enfriar agares, ¡de la muestra a la estufa en 10 segundos!
DryPlates RYM viran de violeta a amarillo en las primeras 18 h si hay presencia de hongos
Empleando Rapid Sabouraud YM Agar para recuento de hongos (levaduras y mohos) y Rapid Cromogenic Agar para recuento de aerobios en cosmética (o PCA Cromogénico en alimentos), el laboratorio deja de sufrir los recuentos como freno durante 5 días a la liberación de los lotes. Y el nuevo freno pasa a ser la detección de patógenos tras enriquecimiento (3-4 días). Lo que ahorra 1-2 dias de stock de producto final en cuarentena. A un coste similar al de la liberación en 5 días.
https://www.microkit.es/fichas/rapid-ym-agar.pdf
¿Qué pensará el empresario si sabe que puede ahorrarse la millonada de 2 dias de stock, sin inversión en técnicas caras, pero su laboratorio todavía no lo está aprovechando?
Haga sus consultas de Rapid Sabouraud RYM Agar en: microkit@microkit.es
Haga sus pedidos de Rapid Sabouraud RYM Agar en pedidos@microkit.es
No se pierda nuestro video: https://youtu.be/qE2gNZH9KWQ?si=sAKHe8KqtGkBua9V